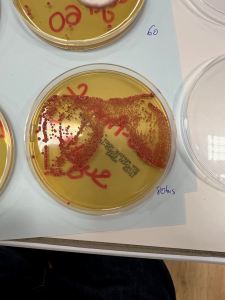
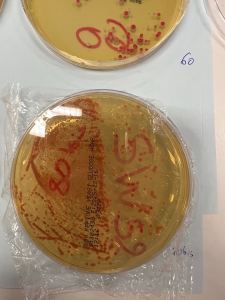
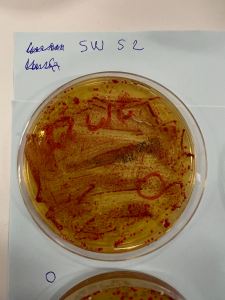
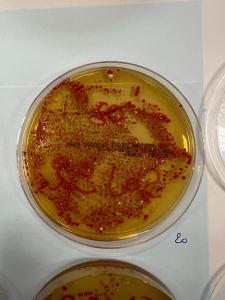
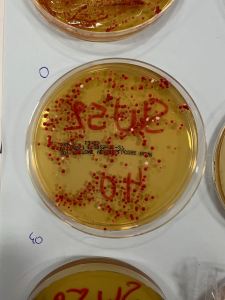
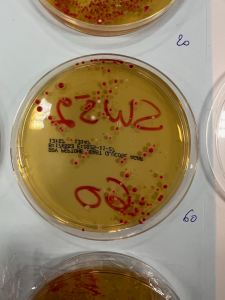
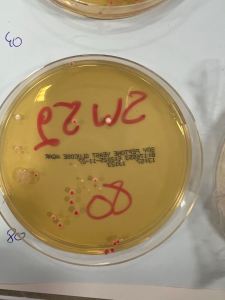

Voici les principaux polys et compléments au thème.
Chapitre B1 : les divisions cellulaires des eucaryotes.
Liens complémentaires:
Mitose.
Méiose.
Comparaison mitose/méiose.
Chapitre B2: la réplication de l’ADN.
Animation de la réplication de l’ADN (certaines notions excèdent le programme).
https://www.youtube.com/watch?v=mqNTJGJ110U
Animation plus précise de la réplication de l’ADN (pour ceux qui veulent aller plus loin et travailler leur anglais).
https://www.youtube.com/watch?v=TNKWgcFPHqw
Exercice: expérience de Taylor. 26_1spe_B2_exercice_v2
Activité pratique. La technique de PCR. 26_1spe_B2_pratiqueB_v3
Résultats de la PCR sur 30 cycles.

La PCR en animation. Lien vers l’animation
Complément: la RT PCR. lien vers les explications
Document de cours. 22_1spe_B2_document
Chapitre B3: mutations de l’ADN et variabilité génétique.
TP agents mutagènes (levures et UV) et mutations du gène de la bêta globine (Geniegen 2).
Résultats obtenus.

Résultats avec lunettes de soleil:
Résultats avec crème solaire (crème solaire à gauche, sans à droite):
Boite 0s:
Boite 20s:
Boite 40s:
Boite 60s:
Boite 80s:
Chapitre B4: l’histoire humaine lue dans son génome.
TP parenté entre humains. 26_1spe_B4_pratique
Chapitre B5: l’expression du patrimoine génétique.
TP transcription, maturation, traduction, échelles du phénotype. 23_1spe_B5_pratique
Exercice sur les échelles du phénotype. 22_1spe_B5_exercice
Des animations de la transcription et de la traduction.
A noter que dans cette dernière animation, les notions d’ARNt et d’anti-codon sont hors programme.
Chapitre B6. Les enzymes, des biomolécules aux propriétés catalytiques.
TP catalyse enzymatique / concentration enzymatique / site actif / spécificité de substrat
Une animation possible de la catalyse enzymatique.
A venir
Laisser un commentaire